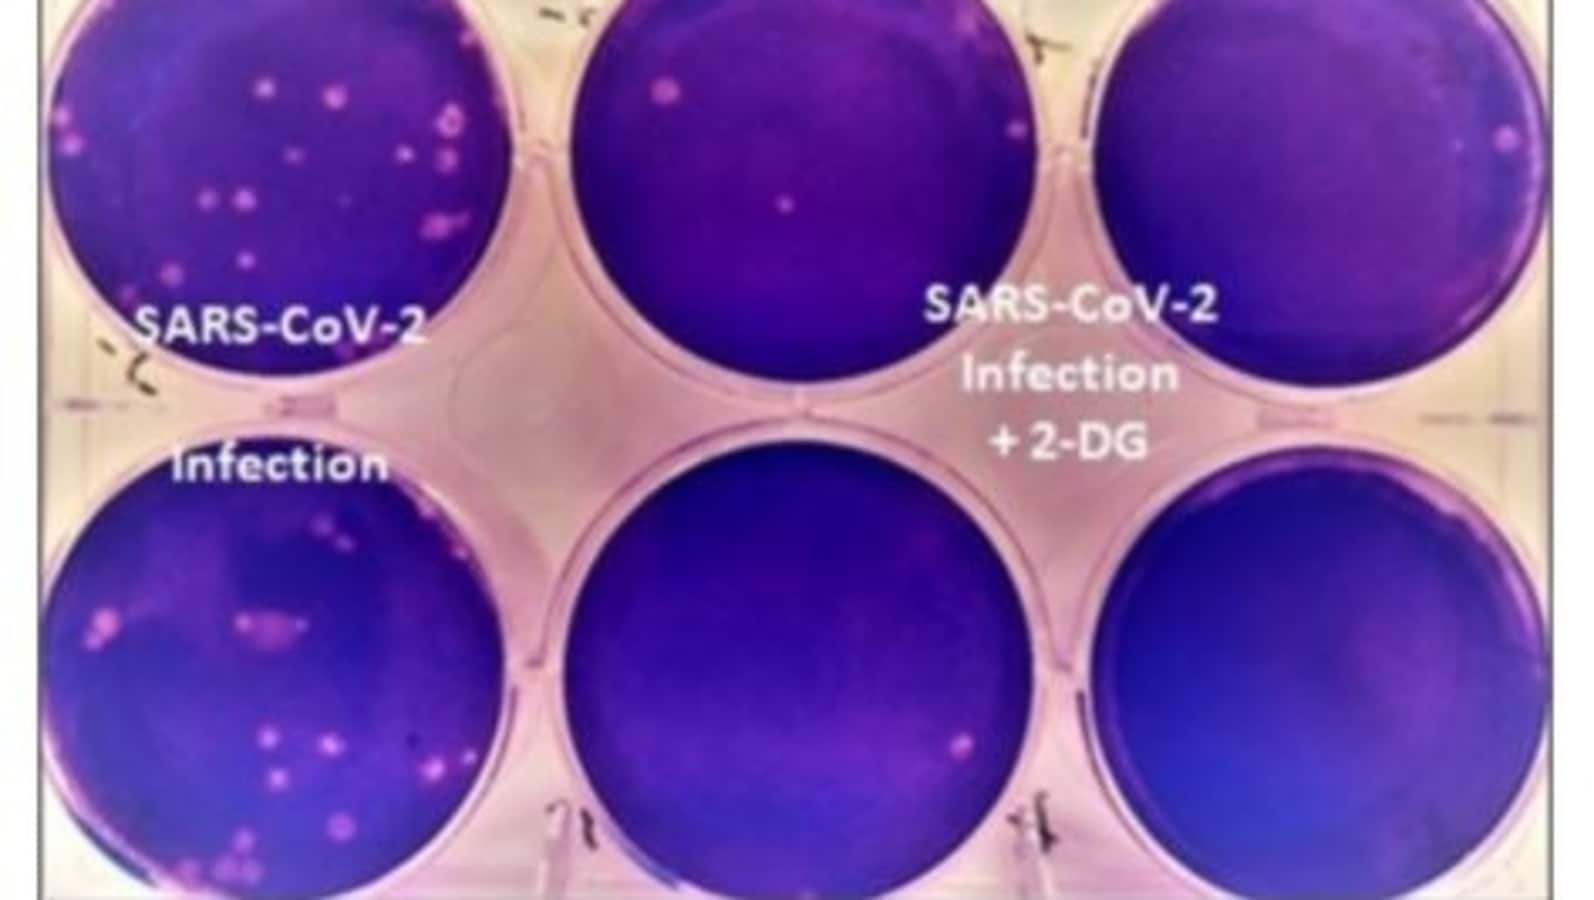

US pipeline company halts some operations after cyberattack
A company that operates a major US energy pipeline says it was forced to temporarily halt all pipeline operations following a cybersecurity attack. In a statement, Colonial Pipeline said the attack took place Friday and also affected some of its information technology systems. “Colonial Pipeline is taking steps to understand and resolve this issue," the company said in a late Friday statement. “The attacks were extremely sophisticated and they were able to defeat some pretty sophisticated security controls, or the right degree of security controls weren't in place," Chapple said. The FBI and the White House's National Security Council did not immediately return messages seeking comment.
Source: Mint May 08, 2021 15:00 UTC